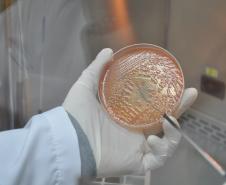
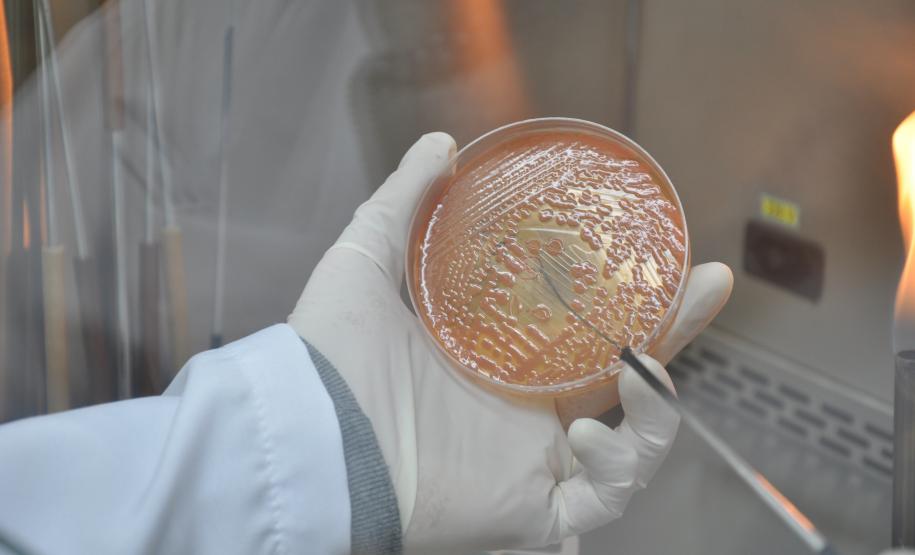
Destinações do IR aumentam 144% Hospital Pequeno Príncipe usa os recursos captados pelo Banco de Projetos em ações de apoio à assistência e pesquisa, formação de pesquisadores, aquisição de insumos e equipamentos. Fotos: Pequeno Príncipe

Destinações do Imposto de Renda para projetos sociais aumentam 144% 02/02/2015 - 10:00
Nos últimos quatro anos, o Paraná registrou um aumento de 144% no valor das contribuições dedutíveis do Imposto de Renda destinadas ao Fundo Estadual da Infância e Adolescência (FIA). No período, pessoas físicas e empresas destinaram R$ 36,3 milhões de parte do imposto que teriam que pagar para financiar projetos sociais desenvolvidos no Estado.
Em 2011, primeiro ano da gestão do governador Beto Richa, as contribuições dedutíveis destinadas ao Fundo somaram R$ 4,5 milhões. No ano seguinte, o montante saltou para R$ 10,2 milhões, valor que aumentou gradativamente e chegou a R$ 10,9 milhões, em 2014.
“As contribuições feitas pelas pessoas físicas e jurídicas são muito importantes porque ampliam os recursos do FIA e ajudam no desenvolvimento de vários projetos sociais voltados para o atendimento a crianças e adolescentes”, diz a secretária do Trabalho e Desenvolvimento Social, Letícia Raymundo.
A secretária lembra que ao destinar parte do Imposto de Renda a ser pago, o próprio cidadão ou empresa pode decidir onde aplicar sua contribuição, o que torna a gestão de recursos mais democrática e participativa.
FINANCIAMENTO – O Fundo para a Infância e Adolescência foi criado com o objetivo de captar recursos para o atendimento de políticas, programas e ações para a proteção de crianças e adolescentes. No Paraná, a administração dos recursos, formalização de convênios e acompanhamento de projetos financiados pelo Fundo é de responsabilidade da Secretaria do Trabalho e Desenvolvimento Social.
Além das políticas públicas, os recursos também podem ser usados para o financiamento de ações por meio de um Banco de Projetos. Nesta modalidade, podem apresentar projetos as organizações, governamentais ou não, que realizam trabalhos de atendimento direto às crianças, jovens e suas famílias em programas protetivos e socioeducativos previstos no Estatuto da Criança e do Adolescente.
“De acordo com a legislação, toda a aplicação dos recursos do FIA passa pela aprovação do Conselho Estadual dos Direitos da Criança e do Adolescente, que também faz a análise dos projetos”, explica a presidente do Cedca, Ires Damian Scuzziatto.
As principais áreas atendidas são: garantia do direito à convivência familiar e comunitária; enfrentamento às violências; erradicação do trabalho infantil; atendimento em situação de risco; prevenção e tratamento a dependência e uso de substâncias psicoativas; atenção aos internados por motivos de saúde e ao adolescente em conflito com a lei.
PROJETOS APROVADOS – Entre as instituições que receberão este ano os recursos destinados ao FIA em 2014 estão a Associação Paranaense de Apoio à Criança com Neoplasia - APCN (R$ 1,9 mil), Pequeno Cotolengo Paranaense (R$ 187 mil), Fraternidade Espírita Allan Kardec – Feak (R$ 500 mil), Instituto de Câncer de Londrina (R$ 60,5 mil), Hospital Erasto Gaertner (R$ 1,1 milhão), e a Associação Hospitalar de Proteção à Infância Doutor Raul Carneiro - Hospital Pequeno Príncipe (R$ 7,83 milhões).
A diretora-executiva do Hospital Pequeno Príncipe, Ety Cristina Forte Carneiro, explica que os recursos do FIA são destinados aos projetos “Avanços em Tratamentos de Saúde” e “Direito à Vida”. Ambos têm como foco o apoio à assistência e à pesquisa, com a formação de equipes de pesquisadores, aquisição de insumos, equipamentos e o financiamento de 20 bolsas de residência médica.
De acordo com Ety, os recursos são fundamentais para a realização de aproximadamente 350 mil atendimentos anuais, 24 mil internamentos e 19 mil cirurgias realizadas na instituição. ”Desde a criação do Banco de Projetos, o hospital tem contado com centenas de apoiadores. Agradecemos à sociedade por este voto de confiança e reconhecimento do trabalho prestado”, diz.
COMO PARTICIPAR – Para receber financiamento, a entidade interessada deve, primeiramente, entregar seu projeto no Escritório Regional da Secretaria do Trabalho e Desenvolvimento Social que assessora o município onde está localizada.
Para atender aos critérios de aprovação, o projeto deve seguir o modelo padrão: apresentar as ações que serão executadas, resultados esperados, custos e a forma de monitoramento e avaliação. Além disso, deve ter abrangência estadual ou regional, ou atender, no mínimo, três municípios.
Após a análise preliminar, a proposta é encaminhada à coordenação responsável pela área em que o projeto se propõe a atuar e receberá o parecer técnico. Depois disso, é encaminhado para a aprovação do Cedca.
“Assim que o projeto for aprovado pelo Cedca e incluído no Banco de Projetos, a instituição está autorizada a captar recursos junto às empresas ou pessoas físicas, por meio da dedução no Imposto de Renda”, explicou Ires.
Em 2011, primeiro ano da gestão do governador Beto Richa, as contribuições dedutíveis destinadas ao Fundo somaram R$ 4,5 milhões. No ano seguinte, o montante saltou para R$ 10,2 milhões, valor que aumentou gradativamente e chegou a R$ 10,9 milhões, em 2014.
“As contribuições feitas pelas pessoas físicas e jurídicas são muito importantes porque ampliam os recursos do FIA e ajudam no desenvolvimento de vários projetos sociais voltados para o atendimento a crianças e adolescentes”, diz a secretária do Trabalho e Desenvolvimento Social, Letícia Raymundo.
A secretária lembra que ao destinar parte do Imposto de Renda a ser pago, o próprio cidadão ou empresa pode decidir onde aplicar sua contribuição, o que torna a gestão de recursos mais democrática e participativa.
FINANCIAMENTO – O Fundo para a Infância e Adolescência foi criado com o objetivo de captar recursos para o atendimento de políticas, programas e ações para a proteção de crianças e adolescentes. No Paraná, a administração dos recursos, formalização de convênios e acompanhamento de projetos financiados pelo Fundo é de responsabilidade da Secretaria do Trabalho e Desenvolvimento Social.
Além das políticas públicas, os recursos também podem ser usados para o financiamento de ações por meio de um Banco de Projetos. Nesta modalidade, podem apresentar projetos as organizações, governamentais ou não, que realizam trabalhos de atendimento direto às crianças, jovens e suas famílias em programas protetivos e socioeducativos previstos no Estatuto da Criança e do Adolescente.
“De acordo com a legislação, toda a aplicação dos recursos do FIA passa pela aprovação do Conselho Estadual dos Direitos da Criança e do Adolescente, que também faz a análise dos projetos”, explica a presidente do Cedca, Ires Damian Scuzziatto.
As principais áreas atendidas são: garantia do direito à convivência familiar e comunitária; enfrentamento às violências; erradicação do trabalho infantil; atendimento em situação de risco; prevenção e tratamento a dependência e uso de substâncias psicoativas; atenção aos internados por motivos de saúde e ao adolescente em conflito com a lei.
PROJETOS APROVADOS – Entre as instituições que receberão este ano os recursos destinados ao FIA em 2014 estão a Associação Paranaense de Apoio à Criança com Neoplasia - APCN (R$ 1,9 mil), Pequeno Cotolengo Paranaense (R$ 187 mil), Fraternidade Espírita Allan Kardec – Feak (R$ 500 mil), Instituto de Câncer de Londrina (R$ 60,5 mil), Hospital Erasto Gaertner (R$ 1,1 milhão), e a Associação Hospitalar de Proteção à Infância Doutor Raul Carneiro - Hospital Pequeno Príncipe (R$ 7,83 milhões).
A diretora-executiva do Hospital Pequeno Príncipe, Ety Cristina Forte Carneiro, explica que os recursos do FIA são destinados aos projetos “Avanços em Tratamentos de Saúde” e “Direito à Vida”. Ambos têm como foco o apoio à assistência e à pesquisa, com a formação de equipes de pesquisadores, aquisição de insumos, equipamentos e o financiamento de 20 bolsas de residência médica.
De acordo com Ety, os recursos são fundamentais para a realização de aproximadamente 350 mil atendimentos anuais, 24 mil internamentos e 19 mil cirurgias realizadas na instituição. ”Desde a criação do Banco de Projetos, o hospital tem contado com centenas de apoiadores. Agradecemos à sociedade por este voto de confiança e reconhecimento do trabalho prestado”, diz.
COMO PARTICIPAR – Para receber financiamento, a entidade interessada deve, primeiramente, entregar seu projeto no Escritório Regional da Secretaria do Trabalho e Desenvolvimento Social que assessora o município onde está localizada.
Para atender aos critérios de aprovação, o projeto deve seguir o modelo padrão: apresentar as ações que serão executadas, resultados esperados, custos e a forma de monitoramento e avaliação. Além disso, deve ter abrangência estadual ou regional, ou atender, no mínimo, três municípios.
Após a análise preliminar, a proposta é encaminhada à coordenação responsável pela área em que o projeto se propõe a atuar e receberá o parecer técnico. Depois disso, é encaminhado para a aprovação do Cedca.
“Assim que o projeto for aprovado pelo Cedca e incluído no Banco de Projetos, a instituição está autorizada a captar recursos junto às empresas ou pessoas físicas, por meio da dedução no Imposto de Renda”, explicou Ires.